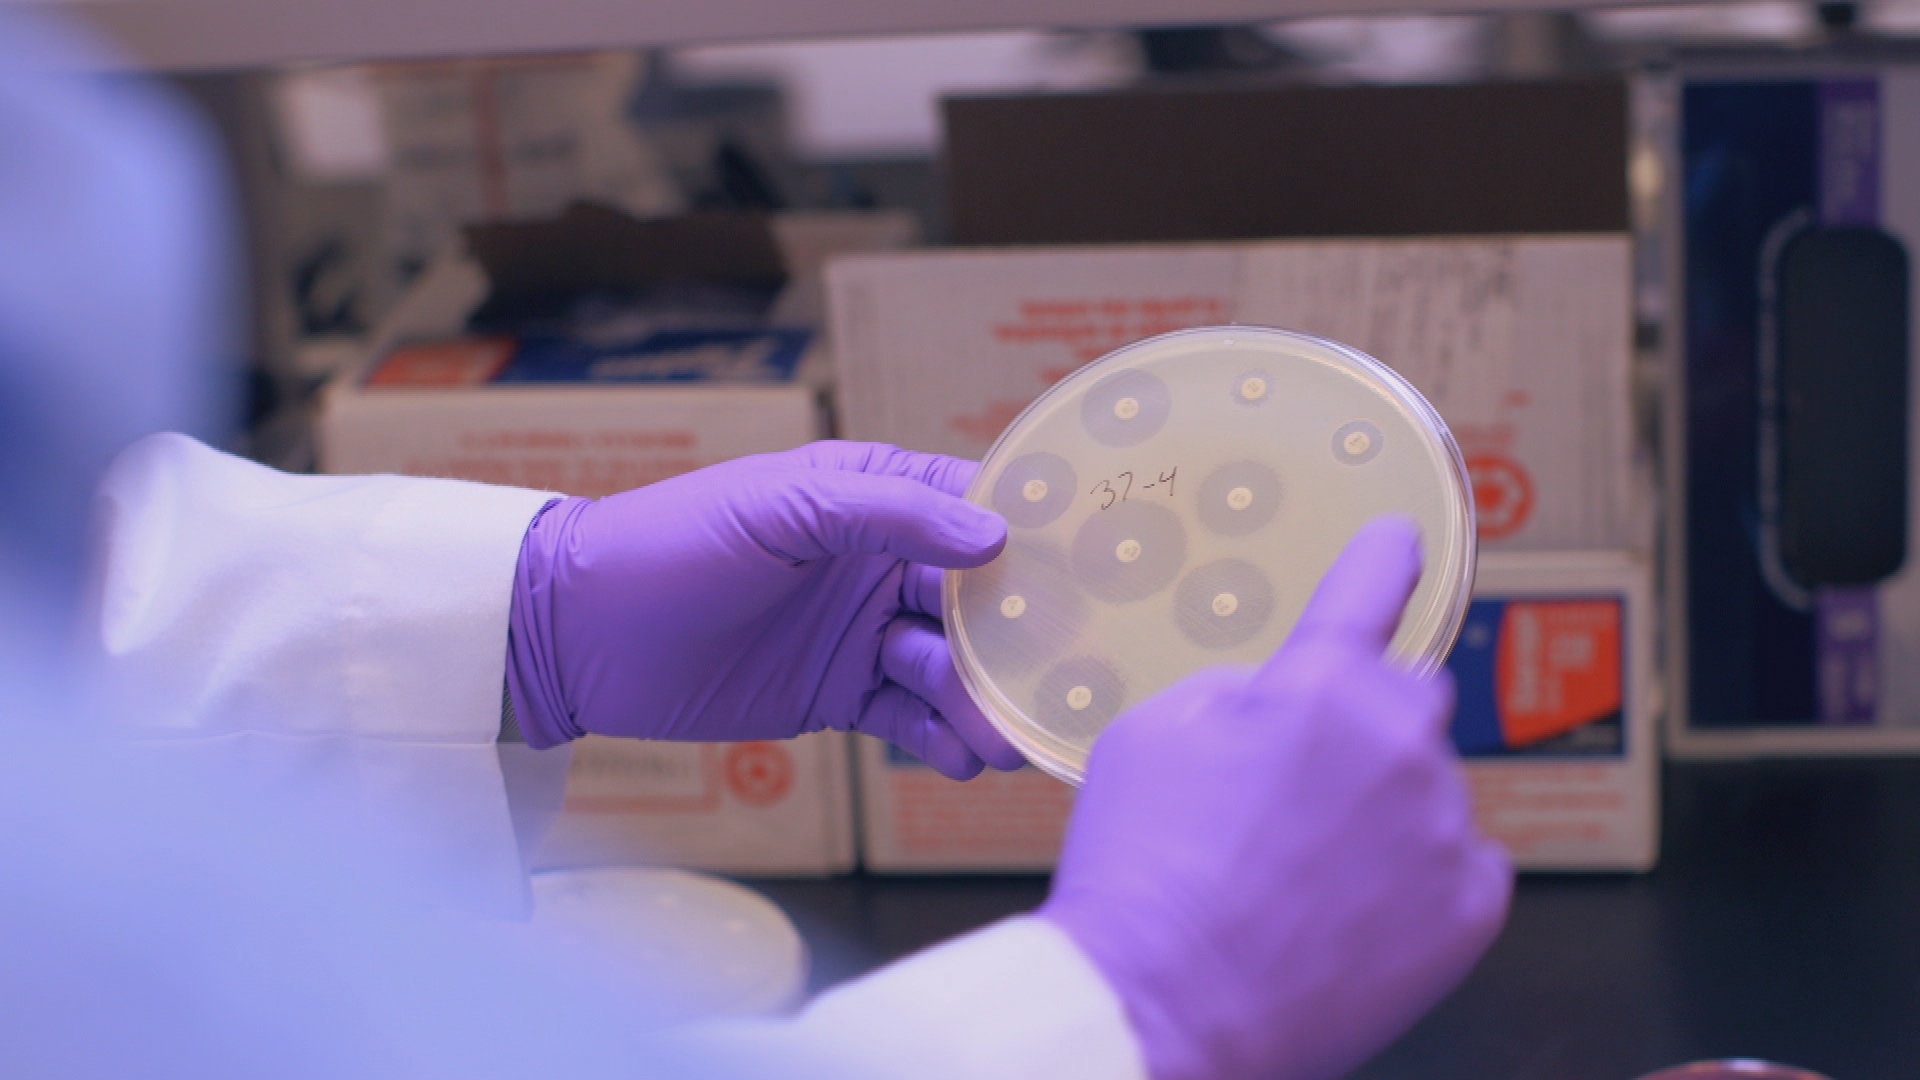
New Report Details the Economic Costs of Superbug Threat

Hunting the Nightmare Bacteria
October 22, 2013
54m
FRONTLINE investigates the rise of deadly drug-resistant bacteria
October 22, 2013
54m
Share
Has the age of antibiotics come to an end? From a young girl thrust onto life support in Arizona to an uncontrollable outbreak at one of the nation’s most prestigious hospitals, FRONTLINE investigates the alarming rise of a deadly type of bacteria that our modern antibiotics can’t stop.
Produced by
Transcript
Credits
Journalistic Standards
Support provided by:
Learn More
The FRONTLINE Newsletter

NARRATOR: This is the story of three seemingly disconnected events beginning at the same time. What they each have in common is a type of infection that is becoming impossible to treat, a type of infection that has triggered deadly outbreaks even at one of our most prestigious hospitals. It is a crisis that is spreading alarmingly fast, threatening everyone, even the healthy.
Our first story starts in Tucson, Arizona, in May 2011.
TONYA RERECICH: When I think about that time, I think about spring and just how─ you know, how busy it was, and how beautiful she was. She was 11-and-a-half years old and just physically perfect, beautiful from head to toe─ slim, you know, with white-blond hair from being out in the sun, a little bit of freckles across her nose, bright blue eyes, paying attention to what her clothes looked like and her hair, never stopped talking, talked a mile a minute.
That was Addie, but that just─ you know, in the month before she got sick.
NARRATOR: Journalist David Hoffman started reporting on the threat of superbugs for FRONTLINE more than four years ago─
NEWSCASTER: There’s a warning from the CDC─
NEWSCASTER: New and extremely dangerous─
NEWSCASTER: ─superbug─
NARRATOR: ─covering what government officials have called a nightmare─
NEWSCASTER: It’s a deadly nightmare bacteria─
NEWSCASTER: The CDC has called it a nightmare.
NARRATOR: ─a kind of dangerous bacteria that is increasingly resistant to the strongest antibiotics.
That’s what brought us to Tucson, Arizona, in 2013, to find out what happened to Addie Rerecich after she complained to her mother about a pain in her hip.
TONYA RERECICH: I thought, “Well, you know, she’s just finishing up softball.” She had been to the track meet, you know, all kind of─ well, it could have been an injury. I gave her some Ibuprofen. As the night wore on, her pain got worse. She didn’t sleep much that night, woke me up a couple of times asking if she could take a hot bath or have another Ibuprofen.
NARRATOR: The next day, Tonya Rerecich, a nurse for 16 years, took Addie to a local hospital, where they said she had symptoms of a virus. But over the next few days, the pain spread and the fever got worse.
TONYA RERECICH: I was afraid at that point. I remember being very afraid. And so I packed a bag and we went to another hospital that had specialized in children’s care. I remember thinking, “She looks bad. This is bad. Something’s really, really wrong.”
They put her on antibiotics. They were─ her blood pressure was dropping. They, you know, were making space in the ICU for her. The next morning, she needed oxygen via mask. They looked at part of her lungs and diagnosed her with pneumonia.
I remember sitting there, watching the sun come up and thinking, “How did she get so sick? How did this happen so fast?”
SEAN ELLIOT, M.D., Infectious Disease Specialist: I met Addie in a hospital bed in the intensive care unit. She was lying there, breathing quickly. She was scared. She had little infected boils all over her body. What really looked most likely when I saw her was a staph bacteria causing septic shock. And Addie fit a pattern that I recognized with community-associated MRSA.
DAVID E. HOFFMAN, Correspondent: When you say community─ I mean, this is what you mean, that a kid picks it up in a playground with a scraped knee, right?
Dr. SEAN ELLIOT: Correct.
NARRATOR: The spread of MRSA, a staph bacteria that causes infections resistant to many antibiotics, has long been a big problem inside hospitals. But over the last two decades, it’s also been found outside, in the community.
Dr. SEAN ELLIOT: In Addie’s case, she was a skin picker. She, as do many kids, picked at her little scabs. And that was likely what introduced the staph infection.
NARRATOR: But the staph was just the start of Addie’s troubles.
Dr. SEAN ELLIOT: She already had evidence of an early pneumonia, and it looked like she was about to get a lot sicker.
TONYA RERECICH: I asked him what were the odds of her making it, getting well.
DAVID E. HOFFMAN: What did he say?
TONYA RERECICH: He said 30 percent. But he had to think about it for a minute, and I knew he was lying to me. I knew. By the time your blood has bacteria in it, you’re in real trouble.
NARRATOR: The staph infection had so damaged her lungs, the doctors had no choice. To save her life, they put her on a lung bypass machine, called ECMO.
TONYA RERECICH: I remember saying, “ECMO?” with a squeaky voice, like, “No! Really? You’re not really talking about ECMO?”
NARRATOR: This was total life support.
TONYA RERECICH: It’s got huge tubes that are put into an artery and a vein. And the patient’s blood comes out of their body, runs through the machine, and the machine does what your lung does.
NARRATOR: The tubes presented a whole new set of dangers.
TONYA RERECICH: Those tubes can harbor bacteria.
NARRATOR: And one of the dilemmas of modern medicine. The interventions that can save you can also put you at serious risk.
Dr. SEAN ELLIOT: Any patient we put on ECMO has a much higher risk of having additional infections. That’s just the nature of the beast.
DAVID E. HOFFMAN: Is that what happened here?
Dr. SEAN ELLIOT: Correct.
DAVID E. HOFFMAN: And she got a particularly nasty one. What was it called?
Dr. SEAN ELLIOT: Stenotrophomonas.
NARRATOR: Stenotrophomonas is an entirely different kind of bacteria from staph. Found in hospitals, it can live inside breathing tubes. And it’s extremely difficult to treat.
Dr. SEAN ELLIOT: The problem with Stenotrophomonas is even at the outset, it’s already a very resistant bacteria. There are only four or maybe five antibiotics normally that are able to treat that particular bacteria.
NARRATOR: Addie was confronting the frightening new face of antibiotic resistance, a group of bacteria called Gram-negatives.
DAVID E. HOFFMAN: So can you explain to me why these Gram-negatives are so stubbornly nasty?
Dr. SEAN ELLIOT: Gram-negative bacteria─ it’s a medical term, and it really references the armor that surrounds the Gram-negative bacteria. That armor makes it very difficult for normal antibiotics to get into the bacteria and to kill it. So Stenotrophomonas is incredibly difficult to treat because it has that serious body armor surrounding it.
NARRATOR: The ability of Gram-negatives to aggressively fight off antibiotics was now playing out in Addie.
TONYA RERECICH: She was first put on one antibiotic that’s good for Stenotrophomonas, and it worked for a while. And then guess what? The antibiotic doesn’t work anymore. Let’s give her a different one. Well, and then it would, you know, work a couple weeks, three weeks. And then the Stenotrophomonas would sort of, like, bloom back up, rear its ugly head, so to speak.
Finally, one day, they said something I never thought I would hear. The Stenotrophomonas is pan-resistant─ “pan” meaning resistant to everything, like a panorama.
NARRATOR: Addie and her mother had entered the post-antibiotic era.
Dr. SEAN ELLIOT: I had to go to her and say, “I don’t have─ I don’t have options based on medical science. I’ve run out of options. I don’t see a way out of this.”
TONYA RERECICH: I remember a long weekend went by. And they had asked me to sign the papers to let her go. And I did.
NARRATOR: There was one only hope left of saving Addie’s life, to surgically remove the infection.
TONYA RERECICH: I remember asking the doctors then about lung transplant. And they said no, that it couldn’t be done, that it would be too dangerous.
Dr. SEAN ELLIOT: The problem was that she was too sick to be transplanted. And that sounds a bit strange because you think of a transplant as the final life-saving thing you’ve got. But because of that resistant Stenotrophomonas, the expected survival of transplanting her was not good. In fact, you might say close to zero.
NARRATOR: Doctors faced a question of medical ethics, whether to risk such a valuable resource as a young set of lungs when Addie’s chances of survival were so low.
DAVID E. HOFFMAN: What tipped the balance?
Dr. SEAN ELLIOT: I think it was Addie’s mom, Tonya, who was such a strong advocate and didn’t give up. And it was also the fact that this was not an unresponsive body lying on the table. This was a young girl who was communicating with us and had temper tantrums and sparks of life, which we could all see on the ECMO apparatus.
I mean, the─ how can you say no to this, you know, living, alive human being who’s communicating with you?
NARRATOR: But Addie would still have to wait in the intensive care unit, hoping to get a new set of lungs.
As Addie was fighting for her life, a 19-year-old American named David Ricci was about to face another threat on the streets of India.
DAVID RICCI: [home video] So after 30 hours on a train, we’ve finally ended up in Calcutta.
NARRATOR: Here, Gram-negatives were spreading in frightening ways, and coming from unexpected places.
DAVID RICCI: I wanted to experience another culture and put myself in an environment where I was serving, where I was helping people. I think India ended up changing me a lot more than I could have ever changed India.
[with children] Eight little monkeys jumping on the bed!
NARRATOR: One morning, the group headed off to work at one of those orphanages, a Mother Teresa home.
DAVID RICCI: It was in the slums of the slums, really, where this orphanage was. So we had to walk through all of these narrow streets that I had never walked through before.
MICHELE FULGINITI, Mission Group Leader: And we basically took a shortcut through the train station. So you crossed over the tracks, and then we were walking adjacent to the train tracks. And as we were going under an overpass─
DAVID RICCI: I was in the very back, walking, and all of a sudden, you know, out of nowhere─
MICHELE FULGINITI: ─a train went by. And I noticed─ I just remember thinking in my head that it went by─ “Wow, that went by really quickly.”
DAVID RICCI: The momentum and the speed hooked my sleeve and ran me over and dragged me underneath the train. The wheel ran over my leg, and I start losing a ton of blood. I just start bleeding everywhere.
NARRATOR: Ricci was pulled from under the train. Lucky to be alive, he was rushed to a local hospital. A doctor came in.
DAVID RICCI: He reached up on the top shelf and he pulls out this leather bundle. And then, you know, he takes out a big knife, you know, a big machete-type-looking saw, knife. And he just starts telling all, you know, the nurses to hold me down and to hold me steady. And then he just started cutting my leg off, just hacking it off.
MICHELE FULGINITI: We were standing outside and we could hear him screaming the whole time.
DAVID RICCI: And then I passed out.
NARRATOR: Within 24 hours, Ricci was moved to another hospital, and his condition deteriorated quickly.
DAVID RICCI: [home video] Hey, everybody. I talked to the doctors. They said I don’t have that much longer. But I’ll put in a good word for you.
NARRATOR: Ricci was barely hanging on.
DAVID RICCI: Miss you all.
NARRATOR: And by the time his family reached India, there were new complications.
CHERYL PERRON, David Ricci’s Mother: They were just telling us, “We need to take him back in for another surgery,” another surgery. And we didn’t understand why. He almost had a surgery every day. And they─ they said, you know, “We’ve got to clean up the infection.” And so, you know, I just thought it’s just an infection, you know? I really didn’t realize what they meant by infection.
NARRATOR: What Ricci and his family didn’t know was that they were on the front lines of a superbug crisis that was just beginning to unfold.
INDIAN NEWSCASTER: The study which found the NDM-1 superbug in Delhi’s water samples is making the Indian health establishment see red.
NARRATOR: Researchers had discovered a new danger.
INDIAN NEWSCASTER: Bacteria carrying the gene that produces this NDM-1 enzyme are resistant to very powerful antibiotics.
RAMANAN LAXMINARAYAN, V.P., Public Health Foundation of India: It absolutely was a bombshell. It was─ it was unexpected.
INDIAN NEWSCASTER: The Lancet infectious diseases journal found that NDM-1 enzyme in 11 different types of bacteria.
NARRATOR: NDM-1 isn’t bacteria, it’s actually a resistance gene that can turn bacteria into superbugs. NDM-1 is resistant to almost all antibiotics. Even more frightening, it is promiscuous─ the resistance gene can jump from bacteria to bacteria, making treatable infections suddenly untreatable.
But there was more. NDM-1 wasn’t just in hospitals. To everyone’s surprise, it was found out in the environment, too.
RAMANAN LAXMINARAYAN: First, from a scientific standpoint, we didn’t realize that this could be done quite so easily. It meant that in places where water and sanitation was poor, where there was going to be lots of bacteria sitting next to each other, that you could have very rapid spread of resistance information across unrelated bacteria just out there in the environment, which is a hugely greater risk than if it were only to happen within the bodies of patients who had these infections.
DAVID E. HOFFMAN, Correspondent: So you’re saying that the bacteria were swapping this information just out there on the street without being in a person.
RAMANAN LAXMINARAYAN: That’s correct. So they could transfer resistance genes even when they were in the same puddle of water.
NARRATOR: With the spread of NDM-1, a much wider population is put at risk. And what has health officials around the world especially worried is that NDM-1 is hearty─ and it travels.
After two weeks in an Indian hospital, David Ricci was flown home to Seattle and taken to the trauma unit at Harborview Medical Center.
JOHN LYNCH, M.D., Infectious Disease Specialist: I first heard about David’s case in July of 2011. I was sitting in my office doing some work, and one of my colleagues, an orthopedic surgeon, Dr. Doug Smith, gave me a call and asking me if I had known about a patient up on one of our acute care floors with a number of drug-resistant pathogens. I brought up his medical record and saw a huge amount of drug resistance, drug resistance we don’t typically see.
All these “R’s” mean that the bacteria is resistant to that antibiotic.
Knowing that David had come from India, I was immediately concerned, even before seeing David, about bacteria in the wound containing this new type of drug resistance.
NARRATOR: Lab results confirmed Lynch’s worst fears. Ricci had brought NDM-1 into the United States. It was one of the first cases to ever be identified here, and Lynch had little to go on.
Dr. JOHN LYNCH: There’s not a lot of clinical experience with treating these bacteria anywhere─ in the literature, there’s no books, there’s no things on it. So we had to figure out what to do for David right then and there.
DAVID RICCI: I get this knock on my door, and they open up the door and there’s these doctors. They tell me, “We need to isolate you. We need to put you on your own and quarantine you.”
NARRATOR: Ricci was in the throes of the NDM-1 nightmare. The gene was spreading resistance to other infections in his leg.
CHERYL PERRON: They showed us the list of them. There were about five bugs. And they said all these infections are resistant to antibiotics. And─ and when they said that, that’s what worried me because I’m, like, “How is he going to get rid of them?”
NARRATOR: Lynch tried several powerful antibiotics, but they didn’t work. He had only one option left, a 1940s antibiotic called Colistin.
Dr. JOHN LYNCH: We went away from it because of its toxicity and the ability to use new antibiotics. The problem now is we don’t have a lot of new options and we’re going back to some of our older antibiotics.
CHERYL PERRON: The hardest part was watching to see what the antibiotics did to him.
DAVID RICCI: It started to eat away at my organs on the inside, you know? I could just feel it, just─ just this poison rushing through my blood.
NARRATOR: The treatment was too toxic.
Dr. JOHN LYNCH: We had to stop the only drug we had left to treat the Gram-negative rods that were in his wounds.
DAVID E. HOFFMAN: You’re telling me that he had these bugs and you had nothing left to treat him with.
Dr. JOHN LYNCH: At this point, we had nothing left to treat him with.
CHERYL PERRON: I just couldn’t believe that there wasn’t an antibiotic that would fix it, to tell you the truth.
NARRATOR: They would have to cut out more of the infection by cutting off more of Ricci’s leg. But it would be months before they knew whether all of the NDM-1 was gone.
A decade ago, hospitals in the New York City area became the epicenter of another highly resistant and deadly type of Gram-negative bacteria. This superbug didn’t come from overseas. This one was homegrown.
It lives in the digestive system, and like NDM-1, it’s a gene that can spread its resistance to other bacteria. It’s called KPC. No one knows exactly how many patients in the New York City area have been infected with KPC or how many have died from it.
Nationally, most hospitals aren’t required to report outbreaks to the government, and most won’t talk publicly about them. But as part of FRONTLINE’s investigation, one of the nation’s most prestigious hospitals, the clinical center at the National Institutes of Health, the NIH, agreed to recount how it dealt with a major KPC outbreak.
It began in the summer of 2011, when a woman carrying KPC was transferred from a New York City hospital here to the NIH in Bethesda, Maryland.
JULIE SEGRE, Ph.D., Geneticist, NIH: Talking about hospital infections is really difficult for a hospital because what you are saying is that we all know that when you come to the hospital, there are certain risks. But we’ve now laid bare what are those risks.
NARRATOR: The NIH had never treated a case of KPC before. And as the patient was brought into the ICU, the staff was determined to keep the KPC from spreading to other patients.
DAVID HENDERSON, M.D., Dpty. Director, NIH Clinical Center: We immediately went on high alert, the equivalent of hospital epidemiology DEFCON 5, trying to implement as many things as we could think of at the time to prevent any further spread of the organism in the hospital.
NANCY AMES, R.N., ICU Nurse, NIH: They called it KPC, and so we learned later that was klebsiella pneumoniae carbapenemase. And that’s a mouthful. But we really didn’t know what that meant.
TARA PALMORE, M.D., Infectious Disease Specialist, NIH: The patient was placed in what we call enhanced contact isolation, which means everybody who went in the room, including visitors, had to wear gloves and gowns.
NARRATOR: The room was at the end of the hall, separate from other patients. But this was the intensive care unit, where patients are very sick and highly vulnerable. And that presented heightened risks.
Dr. DAVID HENDERSON: It’s the kind of place where the bacteria can spread with ease. People are very busy and there are a lot of things going on. Patients get very sick very quickly and require intervention. The bacteria can be spread on the hands. They can be spread on pieces of equipment that might go from patient to patient. So you have to be really cautious.
NARRATOR: Their efforts to contain the KPC appeared to work. When other ICU patients were tested for KPC─
Dr. TARA PALMORE: We found nothing. So at that point, we thought that there had not been spread of the bacteria.
NARRATOR: The New York patient ultimately recovered and was discharged after four weeks in the hospital.
Dr. DAVID HENDERSON: We really felt like we had dodged a bullet.
NARRATOR: But then a big surprise.
Dr. TARA PALMORE: Five weeks later, unexpectedly─
NURSE: Could you do me a favor? Could you get me just a tube fixator out of the R-T closet?
Dr. TARA PALMORE: ─KPC bacteria turned up in a respiratory culture.
NARRATOR: And with it a mystery.
Dr. TARA PALMORE: How this could have spread from the first patient to the second patient.
Dr. DAVID HENDERSON: They were not in ICU at the same time. They didn’t have the same caregivers. They didn’t have the same equipment. So initially, we thought that it might be possible that this was a second introduction of yet another KPC organism.
Dr. TARA PALMORE: I was extremely concerned because the infections with this bacteria had a high mortality rate.
NARRATOR: As they began to investigate, searching for KPC on equipment and testing the patients yet again, they realized the problem was much bigger.
Dr. TARA PALMORE: We started finding other patients in the intensive care unit to whom the bacteria had spread.
NARRATOR: They had an outbreak. The KPC was spreading. The patients were getting sicker. And antibiotics weren’t working.
Dr. TARA PALMORE: And we tried combinations of five, six antibiotics. We tried making oral antibiotics into intravenous antibiotics. We even got an investigational antibiotic from a pharmaceutical company.
DAVID E. HOFFMAN: An experimental one, a test one.
Dr. TARA PALMORE: An experimental antibiotic. And that also did not work.
NARRATOR: Desperate to contain the outbreak, the hospital took unprecedented steps. They created a separate ICU for KPC patients, brought in robots to disinfect empty rooms.
NANCY AMES, R.N., ICU Nurse, NIH: Had monitors here reminding us to wash our hands, built a whole wall up in the other side. We moved every patient in the ICU, completely cleaned it, moved patients back in. And no matter what we did, the bacteria was still─ it was still spreading.
Dr. DAVID HENDERSON: We didn’t know what was going on.
NARRATOR: With the hospital in crisis, genetic researchers in building 49 next door were scrambling to figure out how the KPC was spreading.
JULIE SEGRE, Ph.D., Geneticist, NIH: We had now gotten to the point where they were identifying a patient a week, and it was not clear how these patients might be related to each other.
NARRATOR: Julie Segre and her colleague, Evan Snitkin, started to compare the DNA samples of the KPC taken from the patients.
JULIE SEGRE: Are these all the DNAs then?
EVAN SNITKIN, Ph.D., Post-Doctoral Fellow, NIH: Yeah, these are all the DNAs for─
NARRATOR: Each patient had a number.
EVAN SNITKIN: So this shows you, based on the DNA sequences, how we think the bacteria spread throughout the hospital.
NARRATOR: By matching the DNA, they discovered something none of them knew.
EVAN SNITKIN: Three, four and eight were all silent carriers. And what’s scary about that is they can be transmitting to other patients without anyone knowing that they even have the bacteria themselves. So this─ this bacteria seemed to have been all over the hospital before they had come up positive.
DAVID E. HOFFMAN: And the hospital didn’t know that?
EVAN SNITKIN: They didn’t know because this bacteria has the capacity to live in the stomach of patients without causing infection.
Dr. DAVID HENDERSON: For me, the data were stunning.
DAVID E. HOFFMAN: Why was it stunning?
Dr. DAVID HENDERSON: Because it became very clear that we had missed the transmission sequence.
NARRATOR: The high-tech genomics revealed a disturbing truth─ the outbreak would be much more difficult to contain. And to stop it, they needed to figure out exactly how the KPC was moving through the hospital. Was it on the hands of workers or visitors, or on hospital equipment?
And then, as they urgently searched for silent carriers throughout the rest of the hospital, their worst nightmare came true. The outbreak had spread beyond the ICU.
JULIE SEGRE: That’s a very scary moment. Suddenly, it’s in the general patient population.
NARRATOR: The staff was in a panic. As they looked on helplessly, patients began to die.
NANCY AMES: We felt responsible for it. We are responsible for the patients. You go into a room, and maybe there’s a hole in your glove. It’s a very complex environment. Alarms are ringing. Did you miss something? Did you forget to tell the doctor something? Did I forget to wash my hands between Mr. X and Mrs. Y? Is that why Mrs. Y got KPC?
NARRATOR: There were few options left.
Dr. DAVID HENDERSON: Dr. Gallin asked me if we needed to close the hospital, or if we needed to close the hospital to admissions. Ultimately, we decided not to close the hospital, but─
DAVID E. HOFFMAN: It was a possibility.
Dr. DAVID HENDERSON: Absolutely.
NARRATOR: Instead, they expanded testing hospital-wide and isolated all those found with KPC. Finally, six months after patient one first arrived, the outbreak subsided almost as suddenly as it had begun.
By then, 18 patients had been infected with KPC, and the ultimate tragedy, six people had died from it.
Many inside NIH continued to be concerned.
DAVID E. HOFFMAN: Do you think KPC is now gone from your hospital?
Dr. TARA PALMORE: Oh, no. Absolutely not. I think that─ that we have to be extremely vigilant in the coming years because of the increasing rise, the increasing prevalence of KPCs in the United States.
NARRATOR: The increasing prevalence of threats like KPC became the focus of a five-year study at the world’s largest medical center in Houston. Using cutting-edge genomics, researchers analyzed infections from nearly 1,800 patients, and in May 2017 announced a startling discovery.
JAMES MUSSER, M.D., Ph.D., Houston Methodist: We were surprised, greatly surprised when we found a new type of bacterium that had never been described in great abundance anywhere in the world.
NARRATOR: This new type is called klebsiella CG307, and it can be deadly.
DAVID E. HOFFMAN: Has it killed people?
Dr. JAMES MUSSER: People die with this organism sometimes, yes.
NARRATOR: The rare superbug was found in a third of the samples taken from patients.
Dr. JAMES MUSSER: Now, the question that we don’t know the answer to is why is it abundant? But it’s clearly been abundant here, and undoubtedly in other Houston hospitals, as well.
NARRATOR: And there was a more troubling mystery.
DAVID E. HOFFMAN: Where did it come from?
Dr. JAMES MUSSER: We don’t know exactly where this bacteria came from. But probably, many patients brought it into the hospital, and we now know that this is a common organism in our community.
ARJUN SRINIVASAN, M.D., Associate Director, CDC: The Houston study brings it clear and it puts it there in black and white. The threat of antibiotic resistance is dynamic and ever-evolving.
Dr. JAMES MUSSER: Not only at stake are people’s lives, but as more resistance occurs ─ and I mean nationally, not just in our hospital ─ there’s more of a probability of creating an organism that is now resistant to every antibiotic.
NARRATOR: The prospect of life without antibiotics is barely imaginable for a world that has had a cheap and plentiful supply of them since the end of World War II. They are a staple of modern medicine. It’s hard to recall a time without them, when an infected cut could kill a healthy young person in a matter of days.
But it’s now clear that we are heading back in that direction, that the miracle of these drugs is slipping away.
BRAD SPELLBERG, M.D., Author, Rising Plague: Antibiotics are unique drugs. They’re not like any other class of drugs. Fifty years from today, the cholesterol drugs we have now will work just as well as they work today. The cancer drugs we have now will work just as well as they do today. That’s true of all the other drug classes.
Antibiotics are the only class of drugs that the more we use, the more rapidly we lose. When you use it, it becomes less effective for me, and vice versa.
NARRATOR: That is the essence of antibiotic resistance.
Dr. ARJUN SRINIVASAN: The more you expose a bacteria to an antibiotic, the greater the likelihood that resistance to that antibiotic is going to develop. So the more antibiotics we put into people, we put into the environment, the more opportunities we create for these bacteria to become resistant.
NARRATOR: But people forgot about the danger of resistance because the drugs were so effective.
Dr. BRAD SPELLBERG: And what they had forgotten was the warning that Alexander Fleming himself, the man who discovered penicillin, gave us in 1945, that resistance was already being seen, and the more we wasted penicillin, the more people were going to die of penicillin-resistant infections.
Dr. ARJUN SRINIVASAN: Bacterial resistance is largely inevitable, but it’s also something that we have certainly helped along the way. We’ve fueled this fire of bacterial resistance. These drugs are miracle drugs, these antibiotics that we have, but we haven’t taken good care of them.
NARRATOR: Public health officials estimate that one third of all antibiotic use in the U.S. is either unnecessary or inappropriate.
Dr. ARJUN SRINIVASAN: And in overusing these antibiotics, we have set ourselves up for the scenario that we find ourselves in now, where we’re running out of antibiotics.
NARRATOR: But the growing scarcity of effective antibiotics isn’t just a problem of overuse. It’s also been driven by what’s happening inside the drug industry itself.
JOHN REX, M.D., V.P., Clinical Research, AstraZeneca: The place where it started to turn really challenging, I’d say, would be in the ‘80s and the ‘90s, when we began to see occasional bacteria that were very hard to treat. And it became less obvious that you were able to invent new antibiotics. And the brand-new things just weren’t coming at the same pace.
And then in the ‘90s and the first part of this century, we began to see resistant bacteria for which we really didn’t have very much, or anything at all. And we had nothing coming to treat them.
NARRATOR: That’s because most major drug companies were pulling out of the antibiotic research field just as the Gram-negative threat was worsening. One of the last companies to stay was Pfizer, which had made its name on antibiotics. By the mid-2000s, it had set its sights squarely on the Gram-negative problem.
CHARLES KNIRSCH, M.D., V.P., Clinical Research, Pfizer: We thought there was medical need. That’s really what matters. And we thought that, given our history in being able to develop penicillin, the anti-fungals, you know, antibiotics, that in fact, if we put our minds to it, that we would succeed. But this is a highly risky and unpredictable enterprise.
NARRATOR: Despite the risk, Pfizer built a world-class research team in Groton, Connecticut, and brought in a veteran in Gram-negative research, John Quinn.
JOHN QUINN, M.D., Fmr. Pfizer Antibacterial Adviser: In 1983, when I finished my training, almost every pharmaceutical company had an antibiotic development team. And by the time I landed at Pfizer in 2008, we were really down to three big guys and some smaller companies, biotechs and so on.
And I think all of us felt that, you know, we had a moral obligation to continue to work in this area. There was a pressing clinical need. Most companies had abandoned the field, and we were still in the game. We were proud to still be in the game.
NARRATOR: Quinn and his team believed they were onto something big, several different compounds to treat Gram-negatives. The potential breakthroughs got the attention of the company’s science advisers, including Brad Spellberg.
Dr. BRAD SPELLBERG: I felt that their pipeline was probably the most comprehensive and important anti-bacterial pipeline in the world, focusing on the types of bacteria that we’re really having severe problems with right now.
DAVID E. HOFFMAN: Which are the?
Dr. BRAD SPELLBERG: The highly resistant Gram-negative bacteria. These would have solved problems and saved lives had they been successfully developed.
NARRATOR: But bringing these drugs to market faced the economic paradox of antibiotics.
Dr. JOHN REX: If you need an antibiotic, you need it only briefly. Indeed, that’s the─ that’s the correct way to use an antibiotic. You use it only briefly.
And from an economic standpoint of a developer, that means you’re not─ you’re not getting the return on the investment you’ve made because you’ve spent between $600 million and a billion dollars to bring that new antibiotic to market.
DAVID E. HOFFMAN: Wait. You mean it costs up to a billion dollars to bring a new drug to market?
Dr. JOHN REX: It can easily cost up to a billion dollars to bring a new drug to the market. And the initial reaction to it is, “That’s great, and let’s not use it. Let’s use it as little as possible.”
Dr. BRAD SPELLBERG: So here’s a large company saying, “I have─ I can make billions off cholesterol drugs, blood pressure drugs, arthritis drugs, dementia, things that I know patients are going to have to take every day for the rest of their lives. Why would I put my R&D dollars into the antibiotic division, that isn’t going to make me any money, when I can put it over here, that’s going to make a lot of money for the company? I answer to the shareholders.”
NARRATOR: That was the problem facing Pfizer in 2011. Its stock had plummeted on Wall Street, and its blockbuster cholesterol drug, Lipitor, was about to lose its patent.
JOHN QUINN, M.D., Fmr. Pfizer Antibacterial Adviser: I received an email on my BlackBerry that there was a mandatory emergency meeting in two hours. Can’t be good. So I called in for the meeting and was told that that announcement had been made that the Groton facility was going to be closed.
NARRATOR: The company ended 70 years of leadership in antibiotic development, leaving its search for a Gram-negative cure unfinished.
Dr. JOHN QUINN: The external people who I spoke to, many of whom are personal friends, said to me, “Well, Pfizer’s just doing what other companies have done. There’s nothing particularly wrong with that. It’s not immoral. We are a capitalist society.”
NARRATOR: In 2013, we asked Pfizer to explain the decision.
DAVID E. HOFFMAN: I get the sense that you have to make some very ruthless decisions about where to put the company’s capital, about where to invest, where to put your emphasis. And when you pulled out of Gram-negative research like that and shifted to vaccines, do you look back on that and say, you know, “We learned something about this?”
CHARLES KNIRSCH: These are not ruthless decisions. These are, you know, portfolio decisions about how we can serve medical need in the best way. We want to stay, you know, in the business of providing new therapeutics for the future. Our investors require that of us. I think society wants a Pfizer to be doing what we do in 20 years. We make portfolio management decisions.
NARRATOR: In 2016, Pfizer decided to re-enter the antibiotic market and bought several drugs under development. Like other large pharmaceuticals, though, it is still not investing in research.
BRAD SPELLBERG, M.D., Chief Med. Officer, LAC+USC Med. Ctr.: There is an increasing recognition that antibiotics are not a good thing to run off a pure capitalistic market, OK. We need to switch from an entrepreneurial business model where you maximize sales to other payer mechanisms where the goal is society can say, “We want these kinds of antibiotics developed and we’re going to help you out. We’re going to decrease your cost and risk. In return, on the back end, we’re going to have some say in how it’s used so it doesn’t get abused.”
NARRATOR: In Washington, the federal government has been ramping up its involvement in the superbug fight. Two years ago, the Obama administration unveiled a national plan coordinated by the Department of Health and Human Services. The point person for the effort now is Christopher Jones.
CHRISTOPHER JONES, Ph.D., Dir., Science Policy, HHS: Under the National Action Plan for Combatting Antibiotic Resistant Bacteria, which was released in 2015, we now have an overarching framework and structure for addressing this issue across the federal government.
DAVID E. HOFFMAN: We have a plan.
CHRISTOPHER JONES: We have a plan that has specific actions that are being worked on every single day. And I think it’s reflective of the investments we’ve been making around surveillance, stewardship, developing new products, developing new diagnostics, and increasing international collaboration on the issue.
DAVID E. HOFFMAN: For a long time, people have been warning that the pipeline of new antibiotics is running dry. How’s that going?
CHRISTOPHER JONES: We’re investing $250 million over five years for the early-stage development of antimicrobials. I think the next phase, as we start to think about products that really show promise in early phases, is, how do we continue to support their development? And I don’t think we’ve fully landed on what that strategy looks like, but we do have to rethink how we reward companies, and that’s, again, ongoing conversation.
NARRATOR: But some say the government should be playing a larger role.
DAVID E. HOFFMAN: Is there more that needs to be done?
Dr. BRAD SPELLBERG: Where we need to focus on now is using less antibiotics. We need to create policies and regulations. If we publicly reported antibiotic use, attach requirements to hospitals you have to report, that public shaming effect will drive antibiotic use down.
NARRATOR: Even as the government’s strategy is taking shape, the Trump administration has proposed funding cuts of up to 20 percent to programs and agencies that combat antibiotic resistance.
DAVID E. HOFFMAN: What would be the significance and the impact of new budget reductions in antibiotic resistance?
Dr. ARJUN SRINIVASAN: To your point, yes, a lot of what we’re doing requires investments. It requires resources. If there is less money to spend, there are tough choices that have to be made, things that can’t be done.
Dr. BRAD SPELLBERG: I’m very concerned about it, and I think we all should be. I think the gains that we have made have been largely because of investment. And if we cut back, you’re going to see an even faster evolution of resistance and spread of resistance and way fewer countermeasures being developed to combat it.
NARRATOR: Last year, the warnings became even more dire.
NEWSCASTER: Drug-resistant bacterial infections are on track to kill more people than cancer.
NARRATOR: One international report predicted─
NEWSCASTER: By 2050, superbugs could kill 10 million people a year.
Dr. ARJUN SRINIVASAN: Now we are seeing bacteria that are resistant to the absolute last stop on the train, Colistin. And so for those patients, there are no options left. So those patients are truly─ have gone back in time. They are back in the pre-antibiotic era, and they will recover from those infections or will die from those infections and there’s nothing we can do for them.
NARRATOR: As we reported in 2013, NIH never did fully rid itself of the deadly superbug KPC. A year after the outbreak, a young man came to the hospital because of complications from a bone marrow transplant. While he was there, he contracted KPC and died, the seventh victim of the outbreak.
DAVID HENDERSON, M.D., Dpty. Director, NIH Clinical Center: I guess if I had a major message it would be that it’s never going to end. So this organism and organisms like this are going to be with us until the cows come home, and we have to learn how to deal with them. We have to change our culture in the hospital.
NARRATOR: KPC has been found in hospitals in all but two states. And that’s just the hospitals that are voluntarily reporting it.
As for David Ricci, it took three surgeries and another round of highly toxic antibiotics before doctors believed they had removed all the NDM-1 from his leg.
DAVID RICCI: You know, there’s no muscle left on it, and I’ve only got about six inches left, and the bone stops there.
NARRATOR: So far, Ricci has remained healthy, though not entirely free from the fear of NDM-1.
DAVID RICCI: You know, my doctors were pretty straightforward with me. They were very honest and said, you know, there is a good chance that this infection might not go away.
DAVID E. HOFFMAN: Might not ever go away?
DAVID RICCI: Yeah. Yeah. They said, you know, “We don’t have enough experience to know what’s going to happen.”
NARRATOR: NDM-1 has now spread to at least 70 countries, and here in the U.S., more than 200 cases have been reported.
DAVID E. HOFFMAN: So David was actually sort of a harbinger of something to come.
JOHN LYNCH, M.D., Harborview Medical Center, Seattle: David was an example of something that’s already here. So there are entire continents that have this major problem, public health problem, already. David was simply a sample of that population and new to us. And that’s key because hospitals in any city in the country are going to have patients from all over the world. That globalization, that mobility is going on now. This is already here.
TONYA RERECICH: All right, Addie, let there be light. This is the day that the Lord has made.
NARRATOR: Addie Rerecich was finally able to return home.
ADDIE RERECICH: Yeah, but its, like, not fun. Let there be no light whatsoever. [laughter]
NARRATOR: She received the double lung transplant she’d been waiting for.
TONYA RERECICH: It was like bringing home a premature baby. We brought home monitors. And she couldn’t do anything for herself. She couldn’t even turn over in the bed. She couldn’t turn side to side. That’s how weak and contracted and debilitated she was.
DAVID E. HOFFMAN: So how are you doing now?
ADDIE RERECICH: Basically, I’m fine. Nothing seems out of whack right now. I seem pretty─ I feel pretty good. I look pretty much like I did before. I have all my friends back.
DAVID E. HOFFMAN: Did you understand what was happening to you, or─
ADDIE RERECICH: No.
DAVID E. HOFFMAN: Did anybody talk about infection and what that─ what infection meant?
ADDIE RERECICH: No. Basically, what I was told is─ I’d say, “I want to go home,” and she’d say─ she’d say I couldn’t make the drive home, ever, like I was too sick to go home. [weeps]
TONYA RERECICH: Everything’s hard for Addie now. Everything’s a battle. She has to take a handful of pills twice a day. We have to worry constantly about, you know, picking up a bacteria or a virus. She’s had pneumonia five times, bacterial pneumonia that had to be treated with antibiotics.
And every time, I wonder, is this the time that we’re going to come up against a bacteria that they don’t have anything to treat it with?
I think for lung transplants, the survival rate─ about 80 percent make it a year and about 50 percent make it five years. And every year after that, the risks just go up.
PASTOR: Let’s bow our heads in prayer.
DAVID E. HOFFMAN: But people might say, “The story of Addie is horrible, but that won’t happen to my daughter.” Is this─ could this happen to anybody?
SEAN ELLIOT, M.D., Infectious Disease Specialist: It happened to Addie. She was healthy. It could happen to anybody. It could happen to your next-door neighbor. It could happen to your child. It could happen to anybody.
Now, I’m not here to practice doomsday thinking, but those bacteria are out there and they’re out there in healthy people in the community.
PASTOR: If you don’t mind standing up, you can walk around and─
TONYA RERECICH: The average person thinks, “Oh, I have an infection. I take an antibiotic, I get better.” Yeah, it’s not that simple anymore.
ADDIE RERECICH: [at church social] Good morning, Caleb!
MAN: How’re you doing, sweetheart?
ADDIE RERECICH: I’m good. Thank you.
DAVID E. HOFFMAN: Addie didn’t get better, did she.
TONYA RERECICH: No, she never did get better, really. She didn’t. She had to have surgery and take the infection out, but─
DAVID E. HOFFMAN: May have saved her life.
TONYA RERECICH: For now. Bought her time. That’s what happened. We bought her some time, and I am grateful for every minute of it.
ADDIE RERECICH: Hi, I’m Addie. I don’t think we ever met.
TONYA RERECICH: I remember you. I know I’ve seen you somewhere before!
ADDIE RERECICH: Yeah, me, too! [laughter] Were you my nurse?
TONYA RERECICH: Yeah!
HUNTING THE NIGHTMARE BACTERIA October 22, 2013 Production Credits
WRITTEN, PRODUCED & DIRECTED BY Rick Young
CO-PRODUCER & EDITOR Anthony Szulc
CORRESPONDENT David E. Hoffman
ASSOCIATE PRODUCER & REPORTER Emma Schwartz
ASSOCIATE PRODUCER & ASSISTANT EDITOR Fritz Kramer
CAMERA Tim Grucza Travis Fox
NARRATOR Will Lyman
ADDITIONAL CAMERA Ranu Ghosh Nelson Hume Emma Schwartz Josh Perrault
SOUND Greg Breazeale Jason Canfield Chad Findlay Dave Ryan
ONLINE EDITOR/COLORIST Jim Ferguson
SOUND MIX Jim Sullivan
GRAPHICS Frederick Creative
RESEARCHERS Rachel Estabrook Ravinder Bawa
TRANSCRIPTION Patti Pancoe Suzanne Pardee
MUSIC Music provided courtesy of APM Music
SPECIAL THANKS Public Health Research Institute
ARCHIVAL MATERIAL Astrazeneca Cells Alive Centers for Disease Control and Prevention Getty Images Library of Congress Murdo MacLeod Thean Yen Tan The Wellcome Library U.S. National Library of Medicine U.S. Navy A-4 Nieuws
FOR FRONTLINE
DIRECTOR OF BROADCAST Tim Mangini
ASSOCIATE DIRECTOR OF BROADCAST Chris Fournelle
ON-AIR PROMOTION PRODUCER Missy Frederick
ON-AIR PROMOTION EDITOR John MacGibbon
POST PRODUCTION EDITORS Michael H. Amundson Jim Ferguson
POST PRODUCTION SUPERVISOR
ASSISTANT EDITOR Eric P. Gulliver
SERIES MUSIC Mason Daring Martin Brody
DIRECTOR OF AUDIENCE DEVELOPMENT Pamela Johnston
PUBLICITY ACCOUNT MANAGER Patrice Taddonio
PUBLICIST Diane Hebert-Farrell
ONLINE ENGAGEMENT COORDINATOR Nathan Tobey
SECRETARY Christopher Kelleher
EDITORIAL SECRETARY Sophie Gayter
COMPLIANCE MANAGER Talya Feldman
CONTENT MANAGER Lisa Palone
LEGAL Eric Brass Jay Fialkov Janice Flood Scott Kardel
CONTRACTS MANAGER Gianna DeGiulio
UNIT MANAGER Varonica Frye
BUSINESS MANAGER Tobee Phipps
DIGITAL ASSOCIATE PRODUCER Jason Breslow
DIGITAL TECHNOLOGIST Bill Rockwood
SENIOR DESIGNER Evan Wexler
DIGITAL REPORTER Sarah Childress
ASSISTANT MANAGING EDITOR FOR DIGITAL MEDIA Sarah Moughty
WEBSITE DESIGN AND TECHNOLOGY Entropy Media, LLC
DIRECTOR OF NEW MEDIA & TECHNOLOGY Sam Bailey
DEPUTY STORY EDITOR Carla Borras
COORDINATING PRODUCER Robin Parmelee
SPECIAL COUNSEL Dale Cohen
SENIOR EDITORIAL CONSULTANT Louis Wiley Jr.
SERIES SENIOR EDITOR Andrew Metz
SERIES MANAGER Jim Bracciale
DEPUTY EXECUTIVE PRODUCER Raney Aronson-Rath
EXECUTIVE PRODUCER David Fanning
A FRONTLINE Co-production with American University School of Communication’s Investigative Reporting Workshop
© 2013 WGBH Educational Foundation All Rights Reserved
FRONTLINE is a production of WGBH/Boston, which is solely responsible for its content.
Explore
Policies
Teacher Center
Funding for FRONTLINE is provided through the support of PBS viewers and by the Corporation for Public Broadcasting, with major support from Ford Foundation, and The Fialkow Family Foundation. Additional funding is provided the Abrams Foundation, Park Foundation, John D. and Catherine T. MacArthur Foundation, Heising-Simons Foundation, and the FRONTLINE Trust, with major support from Jon and Jo Ann Hagler on behalf of the Jon L. Hagler Foundation, and Corey David Sauer, and additional support from Koo and Patricia Yuen. FRONTLINE is a registered trademark of WGBH Educational Foundation. Web Site Copyright ©1995-2025 WGBH Educational Foundation. PBS is a 501(c)(3) not-for-profit organization.









